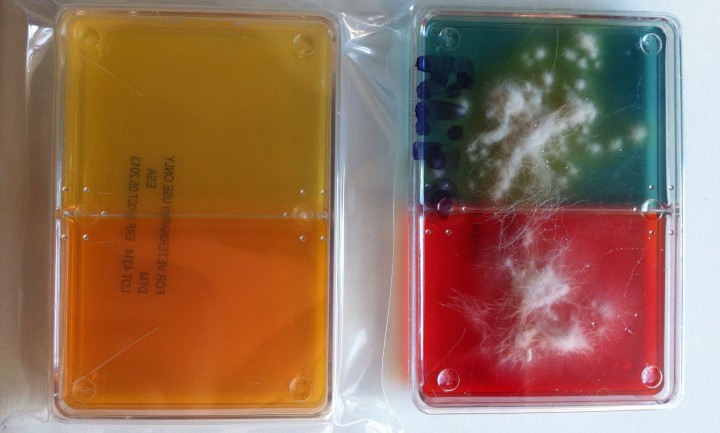
<p><strong>Cultivo DTM (<em>Dermatophyte test medium</em>)</strong>. Consiste en cultivar muestras de piel/pelo obtenidas mediante cepillado (con cepillo dental o similar), depilación (preferible de los pelos fluorescentes al iluminarlos con la lámpara de Wood) o por cinta adhesiva (parece ser la más sensible). Obsérvese en la imagen el resultado positivo por el viraje de color del medio (de naranja o amarillo inicial a rojo o azul final, respectivamente) de forma sincrónica al crecimiento de colonias morfológicamente compatibles con el dermatofito sospechado. Se debe tener cuidado con los falsos positivos, pues los hongos saprófitos pueden dar viraje de color, pero siempre posterior al crecimiento de la colonia.</p>

Dermatofitosis felina
La dermatofitosis (o tiña) es una enfermedad cutánea producida por la infección fúngica superficial de las estructuras queratinizadas de la piel (pelo, estrato córneo y uñas, principalmente). Es mucho más frecuente encontrarla en el gato que en el perro, pero aun así, no es una enfermedad frecuente, representando menos del 3 % de los problemas cutáneos del gato. Según estudios recientes, los dermatofitos no forman parte del microbioma de un gato sano, confirmando así que se trata de una enfermedad contagiosa, por lo que adquiere especial importancia cuando se trata de colectividades de felinos. Los factores de riesgo asociados a su contagio son la edad (más prevalente en gatitos), el estilo de vida (sobre todo animales con salida libre al exterior), vivir en climas cálidos y padecer una enfermedad que inmunodeprima al gato.

Artículos recomendados
Estas recomendaciones se ofrecen de forma automática.
-
Galería de imágenes – Cirugía reconstructiva
Cristina Rizkallal Santana.Clin Vet Peq Anim Vol. 46 - Nº 1 · MAR 2026 · Galería de imágenes
-
Galería de imágenes – Anestesia y analgesia
A. Meneses-García, T. Mangas-Ballester, J. Viscasillas, et al.Clin Vet Peq Anim Vol. 45 - Nº 4 · DIC 2025 · Galería de imágenes
-
Galería de imágenes – Cirugía de tejidos blandos
A. García-Ferrer, N. Vizcaíno-RevésClin Vet Peq Anim Vol. 45 - Nº 3 · SEP 2025 · Galería de imágenes


